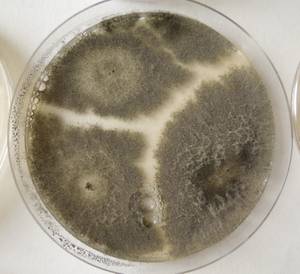
MSU_FS-02624 01, Район Кон Плонг (Kon Plông district), Kon Tum province (Vietnam)
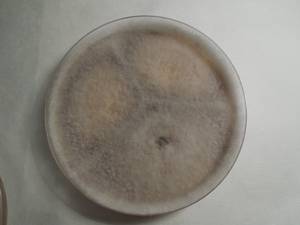
MSU_FS-01534, Район Тан Фу (Tân Phú districts), Đồng Nai province (Vietnam)

Total items: 5
Total pages: 1
Organisms

- Specimen ID
- 0000001189806
- Species
- Scytalidium lignicola
- Strain
- MSU_FS-03309
- Place of isolation
- Район Манг Занг (Mang Yang districts), Gia Lai province (Vietnam)
- Placename
- Адзун (A Yun commune)

- Specimen ID
- 0000001189804
- Species
- Scytalidium lignicola
- Strain
- MSU_FS-03308
- Place of isolation
- Район Манг Занг (Mang Yang districts), Gia Lai province (Vietnam)
- Placename
- Адзун (A Yun commune)
- Specimen ID
- 0000000905704
- Species
- Scytalidium lignicola
- Strain
- MSU_FS-02624
- Place of isolation
- Район Кон Плонг (Kon Plông district), Kon Tum province (Vietnam)
- Placename
- Манг Кань (Măng Cành commune)
- Specimen ID
- 0000000904400
- Species
- Scytalidium lignicola
- Strain
- MSU_FS-01534
- Place of isolation
- Район Тан Фу (Tân Phú districts), Đồng Nai province (Vietnam)
- Placename
- Нам Кат Тьен (Nam Cát Tiên)

- Specimen ID
- 0000000903648
- Species
- Scytalidium lignicola
- Strain
- MSU_FS-00877
- Place of isolation
- Район Винь Куу (Vĩnh Cửu district), Đồng Nai province (Vietnam)
- Placename
- Ма Да (Mã Đà)